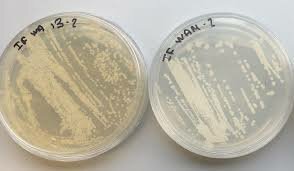
9. Louis Pasteur y las levaduras

-
Los microbios. Se cree que las formas más simples se remonta a 3.500 millones de años en la era Arquea estos tomaron diferentes formas y presentaban en diferentes ramas y sus sintomatología es distinta en las plantas (González, 1980)
-
Permite evidenciar los primeros apariciones de diversas enfermedades tanto en plantas. Donde se puede aclarar que ya son mas de unas 1.415 especies de organismos infecciosos para el hombre, repartidas entre 217 virus y priones, 538 bacterias, 307 hongos, 66 protozoos y 287 helmintos,3 cifra por demás insignificante en el universo microbiano, con más de 70.000 especies de hongos y más de 10.000 especies de bacterias y
virus descritas (González, 1980). -
 se muestra las primeras aprisiones de las enfermedades por domesticación y desarrollo agrícola son asociadas a la cantidad de plantaciones en sitios específicos donde aumenta la proliferación de patógenos se según el tipo de cultivo y las condiciones (Volcy, 2007).
se muestra las primeras aprisiones de las enfermedades por domesticación y desarrollo agrícola son asociadas a la cantidad de plantaciones en sitios específicos donde aumenta la proliferación de patógenos se según el tipo de cultivo y las condiciones (Volcy, 2007). -
 descubrió algunos microbios biológicos aproximadamente en el siglo X. Observo que eran microorganismo capaz de reproducirse o de transferir material genético que afectaban las plantas ya fuera positiva o negativamente (Volcy, 2007).
descubrió algunos microbios biológicos aproximadamente en el siglo X. Observo que eran microorganismo capaz de reproducirse o de transferir material genético que afectaban las plantas ya fuera positiva o negativamente (Volcy, 2007). -
En Mesopotamia, la India, África o América, la superstición y la enfermedad fueron asociados con
1. En lo agrícola se creía popularidades y supersticiosas, con propósitos generales y de las cosechas y otras dirigidas específicamente contra las enfermedades en plantas (Volcy, 2007). -

- las barrera viva son utilizadas en fitopatología como una técnica de control de plagas MIP donde se aleja a los insectos portadores de virus y enfermedades de las plantas. Esto controles favorecen a mantener a las plantas libres de enfermedades y de de insectos que pueden favorecer todo tipo de causas para la muerte de los hospederos (González, 1980).
-
 La orina humana se almacena a temperaturas altas durante varios meses para generar amoniaco, con el aumento del pH obtenido es posible reducir los patógenos con buenos resultados . Además de considerarse como un insecticida es un excelente nutrición para las plantas donde ayuda ha vitalizar las plantas (Munever, 2004).
La orina humana se almacena a temperaturas altas durante varios meses para generar amoniaco, con el aumento del pH obtenido es posible reducir los patógenos con buenos resultados . Además de considerarse como un insecticida es un excelente nutrición para las plantas donde ayuda ha vitalizar las plantas (Munever, 2004). -
- En la agricultura: las primeras enfermedades infecciosas de plantas "samana" y "mehru" en los valles de Mesopotamia donde se cultivaban trigo y cebada antigua india1500-500 a. C (Volcy, 2007).
-
 Los agentes infecciosos son causados por bacterias, hongos, micoplasmas, nematodos y virus que se convirtieron en enfermedades como roya de la cebada o provocaron deformación
Los agentes infecciosos son causados por bacterias, hongos, micoplasmas, nematodos y virus que se convirtieron en enfermedades como roya de la cebada o provocaron deformación
de los granos de cereales. -
En la antigua literatura fitopatológica, especialmente de la India y de Grecia, revela una aproximación a la teoría humoral a las plantas y sus enfermedades, donde se exponía que el humor era algo que se desbalanceaba los líquidos y solidos de una planta haciendo referencia a la interferencia de agentes patógenos en las rices que hacen antagonismo (Volcy, 2007)
-
 Indica la relación que tienen un patógeno para penetrar y formarse dentro de las plantas tomando de los recursos nutricionales de las plantas haciendo una incitación al crecimiento de la enfermedad infecciosa dentro de la planta denominada "Hospedadora".
Indica la relación que tienen un patógeno para penetrar y formarse dentro de las plantas tomando de los recursos nutricionales de las plantas haciendo una incitación al crecimiento de la enfermedad infecciosa dentro de la planta denominada "Hospedadora".
Estos ademas de afectar la planta también afecta el ciclo de vida del hospedante que en este caso es el mismo patógeno (Munever, 2004). -
- La agricultura: la roya provenía de los vapores de los ríos y pantanos y, en general, los vapores nocivos eran una de las causas de las llamadas enfermedades externas, dañaban las plantas.
- El proceso de floración y reducían su rendimiento, especialmente en lugares cálidos en las plantas (Volcy, 2007).
-
 Profesor de Medicina entre 1693 y 1742. Considero que los factores nutricionales en plantas es un indicativo del efecto de patógenos que alteran los solidos (minerales) como consecuencia de el antagonismo de la entrada de solutos (agua y salvia ) en las raíces hacia las tallos y hojas de las plantas y estas alteraciones se reflejaban su estado fisiológico (González, 1980).
Profesor de Medicina entre 1693 y 1742. Considero que los factores nutricionales en plantas es un indicativo del efecto de patógenos que alteran los solidos (minerales) como consecuencia de el antagonismo de la entrada de solutos (agua y salvia ) en las raíces hacia las tallos y hojas de las plantas y estas alteraciones se reflejaban su estado fisiológico (González, 1980). -
- los horóscopos agrícolas fueron muy populares en la agricultura primitiva e indígena (Volcy, 2007). Los antiguos indios indicaron que las cosechas y que las enfermedades procedían de las fases lunares por lo cual eran escogidos y sembrados en solo días específicos de la luna.
- los horóscopos agrícolas fueron muy populares en la agricultura primitiva e indígena (Volcy, 2007). Los antiguos indios indicaron que las cosechas y que las enfermedades procedían de las fases lunares por lo cual eran escogidos y sembrados en solo días específicos de la luna.
-
 Es demostrado que para preservar la salud de las plantas pueden estar asociados a los ciclos lunares donde se pueden evitar enfermedades y plagas a gran escala. la incidencia mas alta es en lunas crecientes afectando el rendimiento y efectos de patógenos (González, 1980).
Es demostrado que para preservar la salud de las plantas pueden estar asociados a los ciclos lunares donde se pueden evitar enfermedades y plagas a gran escala. la incidencia mas alta es en lunas crecientes afectando el rendimiento y efectos de patógenos (González, 1980). -
Esta teoría del Germen no solo se ligo Pasteur y Koch, sino también pensadores de forma empírica y filosófica pero fueron los investigadores dedicados al estudio de enfermedades de las plantas
quienes aportaron la primera y auténtica prueba
experimental (Volcy, 2007). -
 Estas enfermedades son causadas por hongos especialmente y bacterias que son transitorias en cambios de estaciones climatológicas provocando apariciones de enfermedades visuales en las plantas; como el Tizón tardío o Gota de la papa en humedades excesivas (González, 1980).
Estas enfermedades son causadas por hongos especialmente y bacterias que son transitorias en cambios de estaciones climatológicas provocando apariciones de enfermedades visuales en las plantas; como el Tizón tardío o Gota de la papa en humedades excesivas (González, 1980). -
Esta considerada como la teoría del germen apoyada sobre la premisa si solamente dando paso al primero estudio sobre el gusano de seda y la fermentación del vino y de la cerveza.
se descubre la acciòn microbiana en plantas cómo hospedadoras y hospedantes.
permitió también el descubrimiento de agentes de control de patógenos (Volcy, 2007). -
En sus investigaciones aportadas sobre la fermentación del vino y de la cerveza contribuyeron a que hoy en día se aíslen y se repliquen Levaduras de una gran variedad de frutas y plantas que son utilizados en la aplicación de control contra patógenos en las mismas plantas (Munever, 2004)
En sus investigaciones aportadas sobre la fermentación del vino y de la cerveza contribuyeron a que hoy en día se aíslen y se repliquen Levaduras de una gran variedad de frutas y plantas que son utilizados en la aplicación de control contra patógenos en las mismas plantas (Munever, 2004) -
 Es el método que se utiliza para replicación de fitopatógenos donde se puede determinar que la enfermedad se encontraba en el hospedero enfermo y ausente en el hospedero que estaba sano.
Es el método que se utiliza para replicación de fitopatógenos donde se puede determinar que la enfermedad se encontraba en el hospedero enfermo y ausente en el hospedero que estaba sano.
se puede comprobar sintomatología y causas en otros hospederos por medio del contacto inducido o natural de la misma bacteria (González, 1980). -
La diversidad de microrganismos especifican su genero puede interactuar con ciertas características de hospederos siempre y cuando las condiciones ambientales puedan ser propicias para su subsistencia en el hospedero (Volcy, 2007)
-
 Este descubriendo permite evidenciar que los las enfermedades en plantas necesitan de 3 condiciones esenciales para poder desarrollarla. En este caso tiene que existir un agente patógeno como también una planta que sea susceptible a ella y una adecuada climatología en el lugar. Con este método se puede evitar posibles enfermedades y contagios futuras (Munever, 2004).
Este descubriendo permite evidenciar que los las enfermedades en plantas necesitan de 3 condiciones esenciales para poder desarrollarla. En este caso tiene que existir un agente patógeno como también una planta que sea susceptible a ella y una adecuada climatología en el lugar. Con este método se puede evitar posibles enfermedades y contagios futuras (Munever, 2004).
